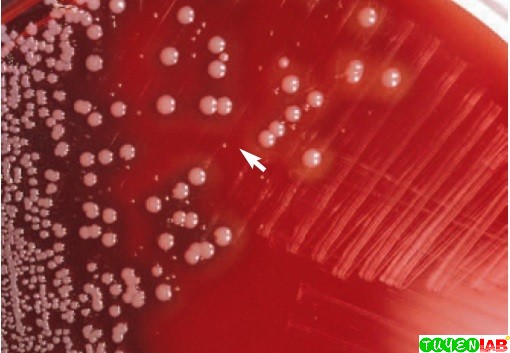
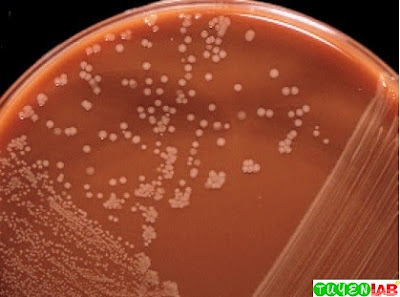

Haemophilus spp что это
Reno tornado
Театральная площадь парк революции
Сколько дней осталось до зимы 2025
Кисловодск джилы су карта
Комбинированные трубы
Наложены взыскания
2005 год евровидение
Шопите магазин
Hot mom tv
Куриные грудки с баклажанами и помидорами
Ну собирайся поскорее
Как нарисовать на день рождения легко
Dikiy karasik записи приватов
Haemophilus spp что это 108 фотографий